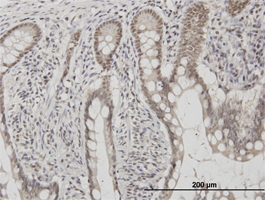

Filters
Clonality
Type
Reactivity
Gene Name
Isotype
Host
Application
Clone
129 results for " Repair" - showing 1-50
Global DNA Methylation, ELISA Kit (Cat# AAA11408)
DNA Damage (8-OHdG), ELISA Kit (Cat# AAA17809)
DNA mismatch repair protein MutS (mutS), Recombinant Protein (Cat# AAA18564)
Alpha-ketoglutarate-dependent dioxygenase AlkB homolog (alkB), Recombinant Protein (Cat# AAA18649)
DNA repair protein XRCC3, Recombinant Protein (Cat# AAA18622)
ERVW-1, Polyclonal Antibody (Cat# AAA21995)
FAN1, Polyclonal Antibody (Cat# AAA23600)
DNA excision repair protein ERCC-1, ELISA Kit (Cat# AAA17733)
DNA repair protein RAD51 homolog 1 (RAD51), ELISA Kit (Cat# AAA11274)
XRCC4, Polyclonal Antibody (Cat# AAA10755)
MSH6, Polyclonal Antibody (Cat# AAA27722)
APEX nuclease (multifunctional DNA repair enzyme) 1, ELISA Kit (Cat# AAA18352)
XRCC3, Polyclonal Antibody (Cat# AAA10739)
Geminin, Monoclonal Antibody (Cat# AAA25406)
Geminin, Monoclonal Antibody (Cat# AAA24224)
Geminin, Monoclonal Antibody (Cat# AAA25701)
Geminin, Monoclonal Antibody (Cat# AAA24815)
Rad50, Polyclonal Antibody (Cat# AAA10640)
MCM2, Monoclonal Antibody (Cat# AAA24858)
C1D, Monoclonal Antibody (Cat# AAA25037)
MCM3, Monoclonal Antibody (Cat# AAA25980)
RAD51C, Monoclonal Antibody (Cat# AAA25223)
RAD51C, Monoclonal Antibody (Cat# AAA24927)
ERCC8, Polyclonal Antibody (Cat# AAA23386)
RAD51C, Monoclonal Antibody (Cat# AAA25813)
C1D, Monoclonal Antibody (Cat# AAA25333)
Geminin, Monoclonal Antibody (Cat# AAA24039)
Purified by Protein A affinity chromatography.